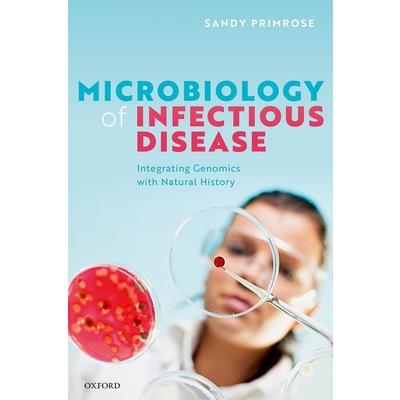
Microbiology of Infectious Disease

Structure and Function of Membrane Proteins
This book examines detailed experimental and computational approaches for the analysis of many aspects vital to the understanding of membrane protein structure and function. Readers will receive guidance on the selection and use of methods for over-expression and purification, tools to characterize membrane proteins within different phospholipid bilayers, direction on functional studies, and approaches to determine the structures of membrane proteins. Detailed experimental steps for specific membrane proteins with critical notes allow the protocols to be modified to different systems. Written for the highly successful Methods in Molecular Biology series, chapters include the kind of practical information and implementation advice that leads to excellent, reproducible results. Authoritative and up-to-date, Structure and Function Studies of Membrane Proteins serves as an ideal guide for biologists, biochemists, and biophysicists striving to furtherunderstand these essential proteins and their many biological roles.
Introduction to Computational Metagenomics
Breakthroughs in high-throughput genome sequencing and high-performance computing technologies have empowered scientists to decode many genomes including our own. Now they have a bigger ambition: to fully understand the vast diversity of microbial communities within us and around us, and to exploit their potential for the improvement of our health and environment. In this new field called metagenomics, microbial genomes are sequenced directly from the habitats without lab cultivation. Computational metagenomics, however, faces both a data challenge that deals with tens of tera-bases of sequences and an algorithmic one that deals with the complexity of thousands of species and their interactions.This interdisciplinary book is essential reading for those who are interested in beginning their own journey in computational metagenomics. It is a prism to look through various intricate computational metagenomics problems and unravel their three distinctive aspects: metagenomics, data engineering, and algorithms. Graduate students and advanced undergraduates from genomics science or computer science fields will find that the concepts explained in this book can serve as stepping stones for more advanced topics, while metagenomics practitioners and researchers from similar disciplines may use it to broaden their knowledge or identify new research targets.
The Miracle of Man
For years, leading scientists and science popularizers have insisted humans are nothing special in the cosmic scheme of things. In this important and provocative new book, renowned biologist Michael Denton argues otherwise. According to Denton, the cosmos is stunningly fit not just for cellular life, not just for carbon-based animal life, and not even just for air-breathing animals, but especially for bipedal, land-roving, technology-pursuing creatures of our general physiological design. In short, the cosmos is specifically fit for creatures like us. Drawing on discoveries from a myriad of scientific fields, Denton masterfully documents how contemporary science has revived humanity's special place in nature. "The human person as revealed by modern science is no contingent assemblage of elements, an irrelevant afterthought of cosmic evolution," Denton writes. "Rather, our destiny was inscribed in the light of stars and the properties of atoms since the beginning. Now we know that all nature sings the song of man. Our seeming exile from nature is over. We now know what the medieval scholars only believed, that the underlying rationality of nature is indeed 'manifest in human flesh.' And with this revelation the... delusion of humankind's irrelevance on the cosmic stage has been revoked."
Single Stranded DNA Binding Proteins
This volume provides a comprehensive set of protocols that can be used by any research lab to investigate diverse functional and structural properties of Single Stranded DNA Binding Proteins (SSBs) from eubacterial, archaeal, eukaryotic, mitochondrial and viral systems. Written in the highly successful Methods in Molecular Biology series format, chapters include introductions to their respective topics, lists of the necessary materials and reagents, step-by-step, readily reproducible laboratory protocols, and tips on troubleshooting and avoiding known pitfalls. Authoritative and cutting-edge, Single Stranded DNA Binding Proteins aims to be a useful practical guide to researchers to help further their study in this field.
Recent Developments on Protein-Ligand Interactions
Protein-ligand interactions play a fundamental role in most major biological functions. The number and diversity of small molecules that interact with proteins, whether naturally or not, can quickly become overwhelming. They are as essential as amino acids, nucleic acids or membrane lipids, enabling a large number of essential functions. One need only think of carbohydrates or even just ATP to be certain. They are also essential in drug discovery. With the increasing structural information of proteins and protein-ligand complexes, molecular modelling, molecular dynamics, and chemoinformatics approaches are often required for the efficient analysis of a large number of such complexes and to provide insights. Similarly, numerous computational approaches have been developed to characterize and use the knowledge of such interactions, which can lead to drug candidates. "Recent Developments on Protein-Ligand Interactions: From Structure, Function to Applications" was dedicated to the different aspect of protein-ligand analysis and/or prediction using computational approaches, as well as new developments dedicated to these tasks. It will interest both specialists and non-specialists, as the presented studies cover a very large spectra in terms of methodologies and applications. It underlined the variety of scientific area linked to these questions, i.e., chemistry, biology, physics, informatics, bioinformatics, structural bioinformatics and chemoinformatics.
Bio-Electrochemical Systems
This book addresses electro-fermentation for biofuel production and to generate high-value chemicals and biofuels using organic wastes. It covers the use of microbial biofilm and algae-based bio-electrochemical systems for bioremediation and co-generation of valuable chemicals, including their practical applications.
Osteoarthritis
In this book, we have reported the most recent discoveries and updates regarding molecular pathways in osteoarthritis. In particular, the advances regarding therapeutical options, from a molecular point of view, are largely discussed.
The Magic School Bus and the Science Fair Expedition
This Reprint aims to present original research articles and reviews concerning the following: Access: affordability, allocation, and preference of food; Availability: the production, distribution, and exchange of food; Circularity in food systems at the local, regional, or global level; Development, impact, and ethics of novel and data-driven technologies in food systems; Food security and policy, governance, institutions, and trade; Influencing food consumption and demand considering the food environment; Stability and dynamics of food security aspects; Sustainable food systems and agro-ecological food production; Utilization: the nutritional value, social value, and safety of food.
Electrophoresis Fundamentals
The electrophoresis techniques are used in medicine, biochemistry, analytical chemistry, and biology to separate soluble and insoluble proteins, nucleic acids, chromosomes, viruses, as well as lysosomes, mitochondria, ribosomes and other cell organelles, red cells, tissue cells, and parasites. This book provides a view over the old electrophoresis techniques, as well as the recent developments in electrophoresis. Electrophoresis Fundamentals is based on the recent book Electrophoresis: Theory and Practice published in 2020 by De Gruyter. The previous book combines theory and technical applications with troubleshooting and problem solving. While Electrophoresis is intended for specialists, Electrophoresis Fundamentals is a book for laboratory technicians, students, biochemists, general practitioners, and more.
Cis-regulatory elements underlying Prdm15 gene during brain development
Bachelor Thesis from the year 2018 in the subject Biology - Genetics / Gene Technology, grade: 2.5, University of Cape Coast (Department of biochemistry - University of Cape Coast), course: Biochemistry, language: English, abstract: The interaction between transcriptional factors and cis-regulatory DNA element has given rise to the diversity in the expression of eukaryotic gene. Prdm15 gene is known to be expressed in the brain throughout development of mouse and zebrafish however; there are no known enhancer(s) for this gene in the brain. The aim of this study was to identify brain specific enhancer(s) for the gene Prdm15 during brain development. The VISTA enhancer browser and Encyclopedia of DNA Elements (ENCODE) data were used in this study to determine our candidate brain enhancer. The VISTA enhancer browser was used to quest for cis-regulatory element(s) in the environs of Prdm15 by comparative genomics and only one candidate enhancer we designated Prdm15 control element 1(PCE1) was identified downstream of the gene. PCE1 was found to be conserved in organisms such as chicken, zebrafish, rhesus, chimp, dog and cow. To ascertain if PCE1 is a brain enhancer, we delineated PCE1 using brain-specific enhancer chromatin modification signatures H3K4me1 and H3K27ac in the ENCODE data and they showed enrichment for PCE1. In conclusion, our data set revealed that only one brain candidate enhancer (PCE1) exist for Prdm15 and that this brain enhancer for Prdm15 will help in identifying important upstream specific transcription factors of PrdmI5 during brain development.
The Amazing World of IDPs in Human Diseases II
This Special Issue includes seven full articles from more than 35 scientists from all around the world working in the amazing field of IDPs. The collected papers unveil novel aspects related to the wide world of IDPs. Using a variety of methods including biochemical, spectroscopic and computational techniques, they represent a step forward in the study and characterization of many IDPs involved in human diseases, with a focus on conformational features, environmental effects, recognition mechanisms and targeting.
Bacillus subtilis as a Model Organism to Study Basic Cell Processes
This book compiles research on the basic cell processes in Bacillus subtilis. The book provides a platform to researchers for sharing their new studies on advances in basic cell processes studies in model organism B. subtilis. The Special Issue includes papers from several leading scientists in the field studying sporulation, biofilm formation, bacteriophages, and transcription in this bacterium and its close relatives.
Microbiology of Infectious Disease
Prior to the advent of rapid DNA sequencing in the late 90s, students were taught in depth about the physiology and ecology of microorganisms. There was a generally good understanding about the biology of each organism and how it interacted with its environment. Since then, the focus of research has shifted towards an analysis of nucleic acid sequences to determine possible cellular biochemistry or phylogeny. A microbial genome can now be sequenced in a matter of hours, and with the help of a panoply of software programmes the inner workings of the organism can be probed in great detail. However, there is now so much detail that the student or researcher tends to lose any sense of the underlying biology of their study organism. Microbiology has almost become a branch of molecular biology, with the biology getting lost in the molecular detail. This novel text reverses that trend by cutting through the molecular information overload and placing the new sequence-derived information in the context of the natural history of the organism in question. Each concise chapter has a fascinating and different story to tell, focussing on one pathogen or group of closely related pathogens and highlighting a particularly interesting and/or unusual feature. The aim is to abstract the relevant molecular and genomic information, and then to show how it provides insights into the biology of the organism as a whole. Microbiology of Infectious Disease is aimed at undergraduates, graduates, and researchers in microbiology, microbial ecology, disease ecology, and related areas. It is intended as a supplemental text for students to provide them with a detailed overview of the biology and natural history of the microorganisms they will routinely encounter and the factors that influence their pathogenicity and infectivity.
Artificial Intelligence (AI) and Machine Learning (ML) in Human Health and Healthcare
This book is a compilation of thirty research articles related to the current trends and techniques in medical informatics and healthcare with the application of Artificial Intelligence (AI) and Machine Learning (ML) to analyze both medical images and Electronic Health Records (EHR) in different domains to develop effective decision support systems as diagnostic aids and screening tools.
Advances in Applied Microbiology
Advances in Applied Microbiology, Volume 121 continues the comprehensive reach of this widely read and authoritative review source in microbiology. Users will find invaluable references and information on a variety of areas relating to the topics of microbiology.
Microbiology of Infectious Disease
Prior to the advent of rapid DNA sequencing in the late 90s, students were taught in depth about the physiology and ecology of microorganisms. There was a generally good understanding about the biology of each organism and how it interacted with its environment. Since then, the focus of research has shifted towards an analysis of nucleic acid sequences to determine possible cellular biochemistry or phylogeny. A microbial genome can now be sequenced in a matter of hours, and with the help of a panoply of software programmes the inner workings of the organism can be probed in great detail. However, there is now so much detail that the student or researcher tends to lose any sense of the underlying biology of their study organism. Microbiology has almost become a branch of molecular biology, with the biology getting lost in the molecular detail. This novel text reverses that trend by cutting through the molecular information overload and placing the new sequence-derived information in the context of the natural history of the organism in question. Each concise chapter has a fascinating and different story to tell, focussing on one pathogen or group of closely related pathogens and highlighting a particularly interesting and/or unusual feature. The aim is to abstract the relevant molecular and genomic information, and then to show how it provides insights into the biology of the organism as a whole. Microbiology of Infectious Disease is aimed at undergraduates, graduates, and researchers in microbiology, microbial ecology, disease ecology, and related areas. It is intended as a supplemental text for students to provide them with a detailed overview of the biology and natural history of the microorganisms they will routinely encounter and the factors that influence their pathogenicity and infectivity.
An Apiary Guide to Swarm Control
There is no doubt that swarm control is simultaneously the most important and most difficult aspect of colony management with which beekeepers have to deal - if they chose to do so, of course. Swarming is also the most complex of the many behaviours that have evolved to enable a honey bee colony to successfully complete its life-cycle. This revised edition incorporates experience that has been gained by the author and others over the eight years since the first edition was written. Having all the necessary equipment to hand when it is likely to be required during the season and good logistics are the key to a successful outcome.. Safe handling of the queen is paramount. Although swarm control is often a matter of some urgency, it is advisable to carefully think through management techniques you are going employ in advance and, above all, keep calm.The beekeeper needs to understand that swarming is simply reproduction. All the complex, integrated behaviour that occurs within a honey bee colony has evolved simply to improve its chance of successful reproduction. Most beekeeper's primary interest is just one aspect of this behaviour, namely the collection of nectar and the storage of honey. In order to produce the maximum amount of harvestable honey, the beekeeper seeks to create large colonies but also to prevent them from achieving their natural destiny through swarming - so there is an inherent conflict involved. The only way of addressing this is through swarm control.In their book entitled `Bait Hives for Honey Bees`, Seeley and Morse state that, `Mature colonies have a natural urge to swarm each year unless weakened by disease or mismanagement`. So perhaps we should not be surprised or regard it as dysfunctional when colonies swarm. Most beekeeping books understate swarming but its control is vital if good honey crops are to be consistently obtained. There is no doubt that swarm control is simultaneously the most important and most difficult aspect of colony management.
Application of Antibody and Immunoassay for Food Safety
The book addressed several critical issues in application of antibodies and immunoassays for food safety. (1) Methodologies for the enhancement of sensitivity, rapidity, and reliability; (2) eliminating food matrix effect; (3) exploiting high-quality antibodies and new specific recognition elements, such as bispecific monoclonal antibody, broad-specific antibodies, and single chain antibody fragment (scFv) mutants; (4) preparing stable and strong signal labels to improve the accuracy and sensitivity of immunoassays; (5) multiple detection abilities as inevitable trends in the immunoassay development, etc.
Fungi in Sustainable Food Production
Presents research on the challenges and potential of fungal contribution in agriculture for food substantiality Includes insights into use of microbial consortia for food processing of biobased products Bridges across topics related to prospects, investment, and intellectual and technical issues related to fungal contribution in agriculture
DNA and RNA Isolation Techniques for Non-Experts
1-Basic idea about nucleic acids for non-experts 2-General steps during isolation of DNA and RNA 3-Phenol-chloroform DNA isolation method 4-RNA isolation by the guanidinium-acid-phenol method 5-Spin column-based isolation of nucleic acid 6-Isolation of plasmid DNA by alkaline lysis 7-DNA Isolation by Hydrophilic Ionic Liquid Treatment 8-Lithium Chloride based isolation of DNA and RNA 9-Isolation of Bacteriophage DNA by PEG Method 10-DNA isolation by Chelex Method 11-DNA isolation by Lysozyme and Proteinase K 12-Salting-out method for blood samples 13-CTAB or SDS based isolation of plant's DNA 14-DNA extraction by spooling method 15-Magnetic bead-based nucleic acid isolation 16-Density gradient-based nucleic acid isolation 17-DNA extraction from agarose gel though paper-strips 18-TRANSFORMATION OR GENETIC MODIFICATION OF CELLS/ORGANISMS 19-GENE CLONING AND VECTORS 20-POLYMERASE CHAIN REACTION (PCR) 21-Southern and Northern Blotting 22-GENOME MAPPING 23-Applications of DNA Sequencing Technologies for Current Research
Stem Cells and Good Manufacturing Practices
This detailed book explores the utilization and delivery of stem cells for therapeutic purposes in patients in the clinic and the tightly controlled Good Manufacturing Practices (GMP) that make these powerful techniques possible. Fully updated and expanded from the first edition, this collection features a new set of protocols to arm stem cell biologists with protocols that are currently being used in a number of well-established facilities around the world. Written for the highly successful Methods in Molecular Biology series, chapters include introductions to their respective topics, lists of the necessary materials and reagents, step-by-step, readily reproducible laboratory protocols, and tips on troubleshooting and avoiding known pitfalls. Authoritative and up to date, Stem Cells and Good Manufacturing Practices: Methods, Protocols, and Regulations, Second Edition serves as an ideal guide for researchers aiming to drive continued improvements to GMP and accelerate new stem cell treatments for patients in need.
Small Non-Coding Rnas
This second edition provides new and updated chapters detailing methods tackling all aspects of small non-coding RNAs biology. Chapters guide readers through customized dedicated protocols and technologies that will be of valuable help decipher the numerous functions of small non-coding RNAs. Written in the highly successful Methods of Molecular Biology series format, chapters include introductions to their respective topics, lists of the necessary materials and reagents, step-by-step, readily reproducible laboratory protocols and key tips on troubleshooting and avoiding known pitfalls. Instructive and practical, Small Non-Coding RNAs: Methods and Protocols, Second Edition aims to be a valuable help and of great interest to a large number of researchers working in the field of RNA or willing to develop RNA studies.
Host-Fungal Interactions
This volume provides readers with essential protocols for dissecting the host-fungus interaction, and engages researchers in study of mammalian disease. Written in the highly successful Methods in Molecular Biology series format, chapters include introductions to their respective topics, lists of the necessary materials and reagents, step-by-step, readily reproducible laboratory protocols, and tips on troubleshooting and avoiding known pitfalls. Authoritative and cutting-edge, Host-Fungal Interactions: Methods and Protocols aims to ensure successful results in the further study of this vital field.
Cryoem
This volume details the most up-to-date cryo-EM techniques from leading researchers. Chapters are organized into four parts with emphasis on electron cryotomography, single particle analysis, and the crystal based cryo-EM methods of 2D electron crystallography, and MicroED for the study of 3D crystals. Written in the highly successful Methods in Molecular Biology series format, chapters include introductions to their respective topics, application details for both the expert and non-expert reader, and tips on troubleshooting and avoiding known pitfalls. Authoritative and cutting-edge, CryoEM: Methods and Protocols aims to serve as an excellent resource on cryo-EM and can serve as the foundation for new researchers to this growing field in structural biology.
Hydrometeorological Extremes and Its Local Impacts on Human-Environmental Systems
This Special Issue of Atmosphere focuses on hydrometeorological extremes and their local impacts on human-environment systems. Particularly, we accepted submissions on the topics of observational and model-based studies that could provide useful information for infrastructure design, decision making, and policy making to achieve our goals of enhancing the resilience of human-environment systems to climate change and increased variability.
Nanobiotechnology for Sustainable Bioenergy and Biofuel Production
Nanobiotechnology for Sustainable Bioenergy and Biofuel Production delivers an overview of the contributions of biofuel production and the most up-to-date advances in nanobiotechnology to a diverse audience ranging from post-graduate students to researchers in biochemical engineering, biotechnology etc.
Industrial Applications of Microbial Enzymes
Microbial enzymes are an important because they can be used for many industrial purposes. In this edited book, leading scientists cover the various aspect of microbial enzymes and their industrial applications. Microbial enzymes expedite various manufacturing processes and contribute to the sustainable development, which is a priority worldwide.
Applications of Artificial Intelligence in Medical Imaging
Applications of Artificial Intelligence in Medical Imaging provides the description of various biomedical image analysis in disease detection using AI that can be used to incorporate knowledge obtained from different medical imaging devices such as CT, X-ray, PET and ultrasound. The book discusses the use of AI for detection of several cancer types, including brain tumor, breast, pancreatic, rectal, lung colon, and skin. In addition, it explains how AI and deep learning techniques can be used to diagnose Alzheimer's, Parkinson's, COVID-19 and mental conditions. This is a valuable resource for clinicians, researchers and healthcare professionals who are interested in learning more about AI and its impact in medical/biomedical image analysis.
Protein Adsorption and Conformational Changes
Protein adsorption to solids, nanomaterials, and biological surfaces is of central interest in many fields, including biomedicine, bioanalytical chemistry, materials engineering, bio-nanotechnology, and basic biomolecular research. Although protein adsorption may sometimes occur with little consequence on molecular structure, interactions with surfaces frequently cause changes in local or global conformations and dynamics, perturbations to secondary structures or tertiary folds, eventually resulting in dramatically altered protein function. Importantly, surfaces may trigger protein misfolding and self-aggregation, or, conversely, promote protein structure formation. The use of nanoscale surfaces to remodel the conformational landscape and the aggregation pathways of amyloidogenic peptides and proteins has been proposed as a promising strategy against several severe human diseases. The rapid growth of applications and technological innovation which is based on or concerned with protein adsorption necessitates renewed efforts to provide molecular-level insights into adsorption-induced protein structural perturbations. In this Special Issue, we gathered the recent findings of experimental and computational investigations that contributed novel insights into protein adsorption with a focus on the structural and dynamic aspects of proteins.
The ABCQ of Conceiving Conception
Francis Etheredge explains what is probably one of the greatest transformations in the whole of nature: the changing outward expression of human development that shows the identity of the person from conception. In these pages, Francis seeks to use what is familiar, ancient, modern, scientific, experiential, personal, and philosophical to help us to appreciate the whole gift of God in the mystery of human conception. At the same time, he appeals to ordinary experience and the human tendency to "image" what we know - allowing him to draw on Scripture to help understand conception and to communicate what we have understood to others. Just as relationships are for the good of all, we can recognize that the completion of human development is a human right for all who are conceived - excluding no one and accepting everyone.
The Naturalist on the River Amazons
The Naturalist on the River Amazons, subtitled A Record of the Adventures, Habits of Animals, Sketches of Brazilian and Indian Life, and Aspects of Nature under the Equator, during Eleven Years of Travel, is an 1863 book by the British naturalist Henry Walter Bates about his expedition to the Amazon basin. Bates and his friend Alfred Russel Wallace set out to obtain new species and new evidence for evolution by natural selection, as well as exotic specimens to sell. He explored thousands of miles of the Amazon and its tributaries, and collected over 14,000 species, of which 8,000 were new to science. His observations of the coloration of butterflies led him to discover Batesian mimicry. The book contains an evenly distributed mixture of natural history, travel, and observation of human societies, including the towns with their Catholic processions. Only the most remarkable discoveries of animals and plants are described, and theories such as evolution and mimicry are barely mentioned. Bates remarks that finding a new species is only the start; he also describes animal behaviour, sometimes in detail, as for the army ants. He constantly relates the wildlife to the people, explaining how the people hunt, what they eat and what they use as medicines. The book is illustrated with drawings by leading artists including E. W. Robinson, Josiah Wood Whymper, Joseph Wolf and Johann Baptist Zwecker. On Bates's return to England, he was encouraged by Charles Darwin to write up his eleven-year stay in the Amazon as a book. The result was widely admired, not least by Darwin; other reviewers sometimes disagreed with the book's support for evolution, but generally enjoyed his account of the journey, scenery, people, and natural history. The book has been reprinted many times, mostly in Bates's own effective abridgement for the second edition, which omitted the more technical descriptions. the best book of Natural History Travels ever published in England - Charles Darwin
Migration and Global Health
This book attests to the ample research needs and opportunities around migration and health, with a focus on recent as well as earlier migration to Europe. It sheds light on several issues ranging from non-communicable disease epidemiology and health services utilization to aspects of quality of life, and of some methodological challenges.
Role of miRNAs in Cancer
MicroRNAs are the best representatives of the non-coding part of the genome and their functions are mostly linked to their target genes. During the process of carcinogenesis, both dysregulation of microRNAs and their target genes can explain the development of the disease. However, most of the target genes of microRNAs have not yet been elucidated. In this book, we add new information related to the functions of microRNAs in various tumors and their associated targetome.
Oncolytic Virus Immunotherapy
Dear Readers, Oncolytic Viruses (OV) are self-propagating agents that can selectively induce the lysis of cancer cells while sparing normal tissues. OV-mediated cancer cell death is often immunogenic and triggers robust anticancer immune responses and immunoconversion of tumor microenvironments. This makes oncolytic virotherapy a promising new form of immunotherapy and OVs ideal candidates for combination therapy with other anticancer agents, including other immunotherapeutics. There are more than 40 OVs from nine different families in clinical development and many more at the preclinical stage. Each OV has its own unique characteristics, its pros and cons. Although herpes simplex virus is currently the lead clinical agent, a real champion among the OVs has not yet emerged, justifying the continuous development and optimization of these agents. This book, "Oncolytic Virus Immunotherapy", summarizes the state-of-the-art and gives a comprehensive overview of the OV arena with a particular focus on new trends, directions, challenges, and opportunities.
Transcriptome Profiling
Transcriptome Profiling: Progress and Prospects assists readers in assessing and interpreting a large number of genes, up to and including an entire genome. It provides key insights into the latest tools and techniques used in transcriptomics and its relevant topics which can reveal a global snapshot of the complete RNA component of a cell at a given time. This snapshot, in turn, enables the distinction between different cell types, different disease states, and different time points during development. Transcriptome analysis has been a key area of biological inquiry for decades. The next-generation sequencing technologies have revolutionized transcriptomics by providing opportunities for multidimensional examinations of cellular transcriptomes in which high-throughput expression data are obtained at a single-base resolution. Transcriptome analysis has evolved from the detection of single RNA molecules to large-scale gene expression profiling and genome annotation initiatives. Written by a team of global experts, key topics in Transcriptome Profiling include transcriptome characterization, expression analysis of transcripts, transcriptome and gene regulation, transcriptome profiling and human health, medicinal plants transcriptomics, transcriptomics and genetic engineering, transcriptomics in agriculture, and phylotranscriptomics.
Biological and Pharmacological Activity of Plant Natural Compounds II
The Special issue "Biological and Pharmacological Activity of Plant Natural Compounds II" is continuing the intriguing research on the use of natural plant products. The second edition follows the aim of the first one.
Neuroendocrine Control of Energy Metabolism
The control of energy metabolism is a central event for cell, organ, and organism survival. There are many control levels in energy metabolism, although in this Special Issue, we concentrated on the neuroendocrine control which is operated through specialized neural circuits controlling both food intake and energy expenditure. Due to the explosion of obesity and associated diseases, the subject of this Special Issue is of particular interest today.
Biobanks in Low- And Middle-Income Countries: Relevance, Setup and Management
This book introduces the fundamentals of biobanking and guides through the practical planning thereof, with a special focus on the situation in low- and middle-income countries. On the example of the setup of a Ukrainian biobank the book discusses the main steps and aspects of successful biorepository implementation and management. Topics covered include collection, storage and shipping of samples, establishment of an IT system, development of a sustainability plan, and project and risk management. Furthermore, the importance of the formation of international biobanking societies such as the Ukraine Association of Biobanks is highlighted, and their main objectives and tasks are discussed.The book addresses life science and business professionals as well as national authorities who are interested in biobanking in general and in setting up a biobank in particular.
Esr Spectroscopy for Life Science Applications: An Introduction
This installment in the Techniques in Life Science and Biomedicine for the Non-Expert series aims to describe ESR spectroscopy as a tool for different applications, such as Healthcare & Pharmaceutical Science, Paleontology & Geochronology and Food Science. In keeping with the series theme, this text is presented in such a manner that the amateur researcher or graduate student can absorb it, while highlighting recent advances and applications of the field. Chapters include solved examples and questions to reinforce themes and encourage readers to apply what they've learnt. ​
Direct Natural Gas Conversion to Value-Added Chemicals
This book provides a broad spectrum of new developments and includes all aspects of direct natural gas conversion including fundamental chemistry, different routes of conversion, catalysts, catalyst deactivation, reaction engineering, novel conversion concepts, thermodynamics, heat and mass transfer issues, system design, and R&D.
Beloved Beasts
In the late nineteenth century, humans came at long last to a devastating realization: their rapidly industrializing and globalizing societies were driving scores of animal species to extinction. In Beloved Beasts, acclaimed science journalist Michelle Nijhuis traces the history of the movement to protect and conserve other forms of life. From early battles to save charismatic species such as the American bison and bald eagle to today's global effort to defend life on a larger scale, Nijhuis's "spirited and engaging" account documents "the changes of heart that changed history" (Dan Cryer, Boston Globe).With "urgency, passion, and wit" (Michael Berry, Christian Science Monitor), she describes the vital role of scientists and activists such as Aldo Leopold and Rachel Carson, reveals the origins of vital organizations like the Audubon Society and the World Wildlife Fund, explores current efforts to protect species such as the whooping crane and the black rhinoceros, and confronts the darker side of modern conservation, long shadowed by racism and colonialism.As the destruction of other species continues and the effects of climate change wreak havoc on our world, Beloved Beasts charts the ways conservation is becoming a movement for the protection of all species including our own.
Ulva reticulata, Halymenia durvillei & Sargassum cristaefolium
This book discusses the nutraceutical composition and properties of three selected marine seaweeds viz Ulva reticulata, Halymenia durvillei and Sargassum cristaefolium from Patikul Higad, Patikul, Sulu and Paayas, Burgos, Ilocos Norte. The proximate and heavy metal compositions of the seaweeds are discussed. Qualitative phytochemical screenings are applied, and antimicrobial components of the algal extract were tested against the pathogens, Escherichia coli and Staphylococcus aureus using paper diffusion. Antioxidant properties of seaweed extracts are assessed using diphenyl-p-picrylhydrazyl. Aside from determining proximate composition, the book also evaluates the heavy metal concentrations in seaweeds. Among the metals analyzed, zinc registered the highest concentration (328.74 mg/kg) in U. reticulata. Other evaluated seaweed species had lower concentrations of copper (Cu), mercury (Hg), and lead (Pb). The concentration reveals that these seaweeds could be a source of the micronutrient -copper. In addition, except for U. reticulata growing, all other seaweeds are safe for human consumption and could be used as raw material for other purposes such as drug or cosmetics preparation.
An Anthropogenic Table of Elements
An Anthropogenic Table of Elements provides a contemporary rethinking of Dmitri Mendeleev's periodic table of elements, bringing together "elemental" stories to reflect on everyday life in the Anthropocene.Concise and engaging, this book provides stories of scale, toxicity, and temporality that extrapolate on ideas surrounding ethics, politics, and materiality that are fundamental to this contemporary moment. Examining elemental objects and forces, including carbon, mould, cheese, ice, and viruses, the contributors question what elemental forms are still waiting to emerge and what political possibilities of justice and environmental reparation they might usher into the world.Bringing together anthropologists, historians, and media studies scholars, this book tests a range of possible ways to tabulate and narrate the elemental as a way to bring into view fresh discussion on material constitutions and, thereby, new ethical stances, responsibilities, and power relations. In doing so, An Anthropogenic Table of Elements demonstrates through elementality that even the smallest and humblest stories are capable of powerful effects and vast journeys across time and space.
An Anthropogenic Table of Elements
An Anthropogenic Table of Elements provides a contemporary rethinking of Dmitri Mendeleev's periodic table of elements, bringing together "elemental" stories to reflect on everyday life in the Anthropocene.Concise and engaging, this book provides stories of scale, toxicity, and temporality that extrapolate on ideas surrounding ethics, politics, and materiality that are fundamental to this contemporary moment. Examining elemental objects and forces, including carbon, mould, cheese, ice, and viruses, the contributors question what elemental forms are still waiting to emerge and what political possibilities of justice and environmental reparation they might usher into the world.Bringing together anthropologists, historians, and media studies scholars, this book tests a range of possible ways to tabulate and narrate the elemental as a way to bring into view fresh discussion on material constitutions and, thereby, new ethical stances, responsibilities, and power relations. In doing so, An Anthropogenic Table of Elements demonstrates through elementality that even the smallest and humblest stories are capable of powerful effects and vast journeys across time and space.
Advances and Novel Treatment Options in Metastatic Melanoma
The book presents several studies reporting advances on melanoma pathogenesis, diagnosis and therapy. It represents a milestone on the state of the art, updated at 2021, and also presents the current knowledge on the future developments in melanoma field.